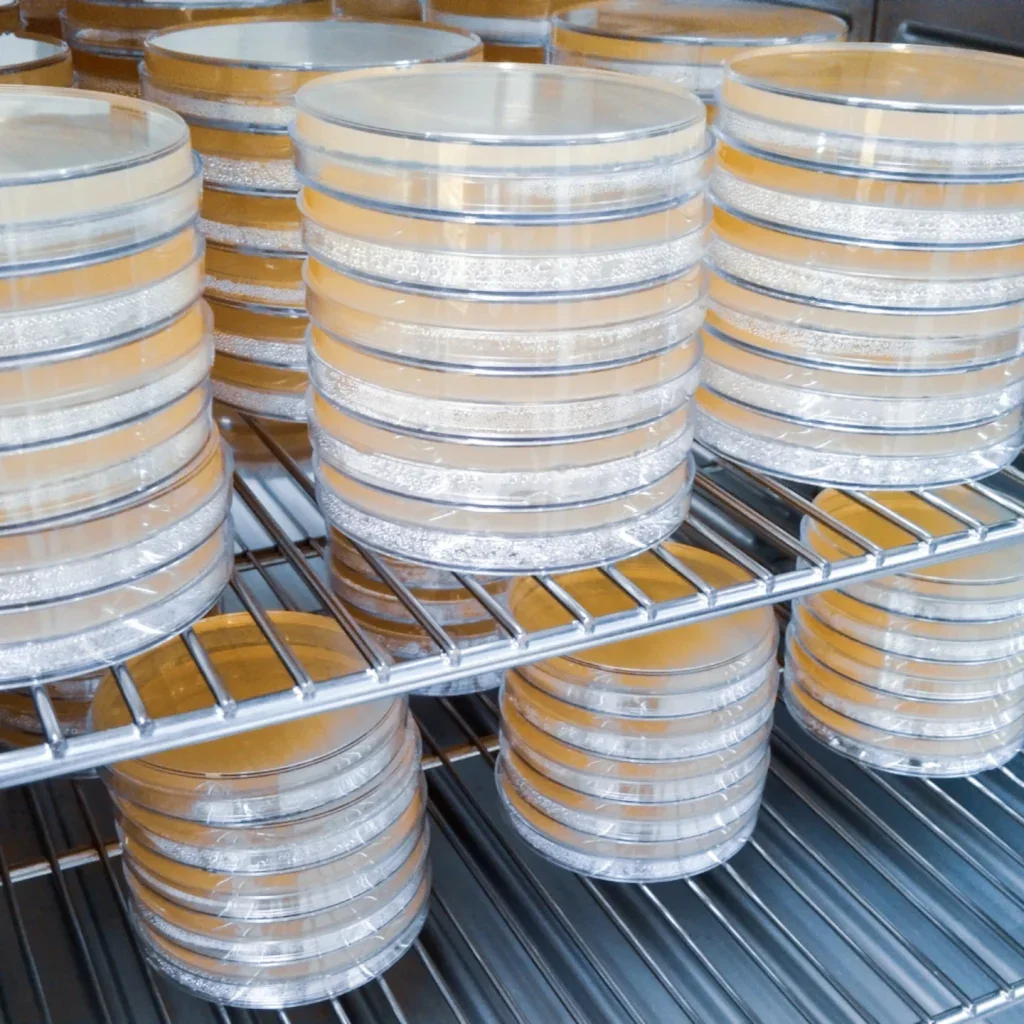

All articles by Staff Writer
Cormica Invests in New Incubators to Enhance Microbiology Testing Capabilities
Cormica is pleased to announce a significant investment in new incubators for Wickham Micro, one of the UK’s largest microbiology laboratories. This upgrade is part of our ongoing commitment to improving patients’ lives by providing comprehensive testing services, enabling clients to launch and release their products safely and rapidly across the world.
Growing demand for monitoring systems: Two non-invasive patient monitoring experts establish a commercial partnership to co-promote technologies
Nonin Medical, a leading provider of SpO2 monitoring solutions and Corscience, a leading provider of CO2 monitoring solution have entered into a partnership to co-promote each other’s OEM product offerings. The two experienced manufacturers are collaborating to better serve both the US and European markets with the highest quality patient monitoring offerings.
MEDICA and COMPAMED 2024: Optimized Layout Enhances Visitor Experience
The upcoming MEDICA and COMPAMED 2024 trade fairs in Düsseldorf are set to showcase the latest innovations in medical technology and healthcare. With over 6,000 exhibitors from 70 countries, the events will occupy the entire exhibition grounds from November 11-14, 2024.
Cormica‘s Laboratory, MET Achieves First-Time FDA Inspection Success
Cormica, as a global leader in comprehensive microbiological, analytical and physical testing services, upholds a commitment to quality across all its world renown laboratories. Our accreditations include Good Manufacturing Practice (GMP), Good Laboratory Practice (GLP), ISO 17025, and recognitions from leading regulatory bodies such as the Medicines and Healthcare products Regulatory Agency (MHRA), the US Food and Drug Administration (FDA), and the United Kingdom Accreditation Service (UKAS). These certifications validate our dedication to excellence, enabling us to support clients in launching and releasing their products safely and rapidly worldwide.
HARTING AG – The Future of Wearable Tech: Smaller, Smarter, and More Comfortable with 3D-Circuits
HARTING is a global leader in the field of electrical and electronic connectors, device terminations, and network components, as well as ready-to-use systems
Europe’s fastest-growing MedTech event, Medical Technology Ireland, returns on 25-26 September 2024 to Galway Racecourse, Ballybrit.
Medical Technology Ireland is Europe’s second largest MedTech Exhibition and Conference, reflecting the dynamic medical device industry in Ireland.
Sony Develops Proprietary Microsurgery Assistance Robot
Prototype first unveiled at ICRA2024 Sony Booth
Cybersecurity in Wearable Technologies
Smart, connected devices are driving the future of healthcare – but they have also given cyber criminals more leverage than ever before to bring hospitals to a standstill. Elly Earls caught up with experts in the industry to find out how cyber threats to the medical device industry have evolved, how manufacturers and regulators are responding and why they can’t let up now.
Updated Medical Device Legislation
In 2017, new regulations were introduced to modernise the European legal framework for medical devices and in vitro diagnostics. But the transition to the new rules has been slow. Elly Earls sits down with Petra Zoellner, Director of Regulatory Affairs (IVDR & MDR) at MedTech, and Richard Houlihan, CEO of EUDAMED consultancy EirMed, to find out how the new legislation could improve device availability and transparency, what challenges manufacturers are facing transitioning to the new framework and why authorities need to hear about them.
Automation in Medical Device Manufacturing
Automated assembly lines are a relative norm in medical device manufacturing – but what does that actually mean? It’s easy to think of automating as a monolithic process rather than the countless technological developments that have made it a reality; and yet even when all of these are applied, it’s not always possible to have the hands-off production process many people imagine when they hear the word automation. Sarah Harris speaks to David E. Williams, president at Health Business Group, and Jennifer Samproni, chief technology officer at Flex, to learn how the world of medical device manufacturing has evolved to integrate more machinery and software and less human hands.